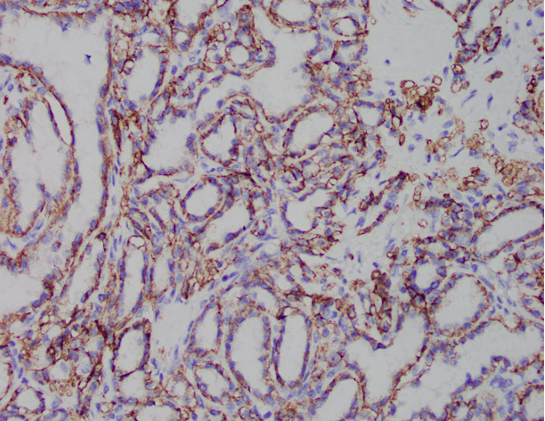
Ahmed_2023_Case_4.png

Case History
A 61-year-old female presents with a 3.5 cm renal mass. Provided are the H&E and CA9 IHC slides which show a cytoplasmic, cup-shaped distribution. CK7 shows diffuse membranous/cytoplasmic staining and AMACR and CD10 are both negative (not shown here).

What is the diagnosis?
A. Clear cell papillary renal tumor (formerly called clear cell papillary renal cell carcinoma)
B. Clear cell renal cell carcinoma
C. Papillary renal cell carcinoma
Correct Answer A. This is a case of a clear cell papillary renal tumor (formerly called clear cell papillary renal cell carcinoma).
Discussion:
- Indolent tumor with clear glycogen-rich cytoplasm, luminal nuclear polarization, inconspicuous nucleoli, and with papillary or tubular architecture with fibrovascular stroma
- Distinctive immunohistochemical profile: positive CK7 and CAIX showing a cup-like pattern, with negative or patchy CD10 and AMACR
- Renamed in WHO 5th edition to reflect indolent behavior (previously designated as a renal cell carcinoma)
- Typically lacks features of high-grade malignancies, including necrosis and vascular invasion
References:
Shen DL, MacLennan G. Clear cell papillary renal cell tumor. PathologyOutlines.com website. https://www.pathologyoutlines.com/topic/kidneytumorclearcellpapillary.html.
Case contributed by: Raheel Ahmed, M.D. Surgical Pathology Fellow, UAB Pathology